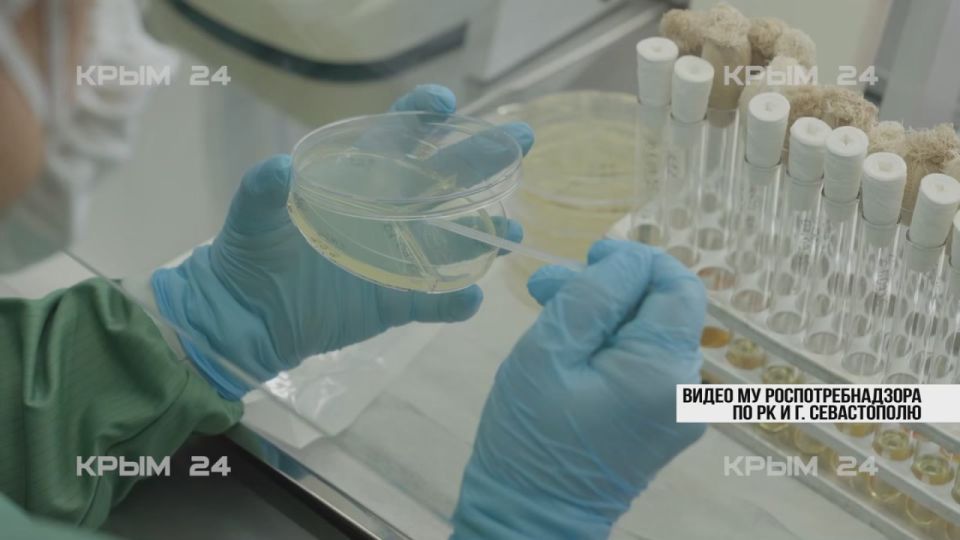
���������� ������������� ������� ���������������� � �����������

Новости за 15.09.2025
15 сентября в России стартует всероссийская литературная акция «Сокровища русской классики». Она проходит в рамках культурно-образовательного проекта «Культура для школьников» и посвящена юбилеям великих писателей и поэтов — Александра Грибоедова (230...
"Также будет проведен капремонт до 4 млн квадратных метров с заменой 1 935 лифтов и реализовано более 34 проектов жилищного строительства", — отметил Ирек Файзуллин.Министр отметил, что благодаря свободной экономической зоне с 2023 года в Херсонской и...
Программа визита первого заместителя губернатора Херсонской области Павла Валерьевича Шувалкина была насыщенной и включала в себя ключевые социальные и экономические объекты округа.Павел Валерьевич посетил Новокаховскую школу №1...
Разведка обнаружила, что противник укрылся в заброшенных ангарах, обустраивая новые позиции. После уточнения координат с помощью дрона, расчёт гаубицы «Мста-Б» отработал безупречно. Все снаряды достигли цели.Подпишись...
Комплекс поможет контролировать эпидобстановку по особо опасным инфекциям в Крыму, Херсонской и Запорожской областях.«Крым 24» теперь в MAX
Тематические книжные выставки оформили в библиотеках Геническа, Новодмитровки, Стрелкового, Алексеевки, Новоалексеевки, Павловки, Новогригоровки и Азовского. Экспозиции представили широкий спектр литературы, посвященной истории...
"Благодаря вам, многим поколениям ваших предшественников – талантливым врачам и учёным – в России создана уникальная система санитарного и эпидемиологического контроля".Сегодня президент открывает по видеосвязи объекты...
"Для Херсонской области сотрудничество с таким передовым партнером имеет особое значение. Обсуждаем поставки современного медицинского оборудования для наших больниц, запуск совместного производства оптических медицинских приборов...
Новую Каховку с дружеским визитом посетила делегация волонтеров из Ставропольского края!Их визит — это прекрасный пример межрегионального сотрудничества и искренней, бескорыстной помощи. В рамках своего визита гости пообщались с жителями, обменялись...
По словам министра обороны, большая часть средств пойдёт на продукцию эстонских военных предприятий, которую передадут Киеву.телеграм-канал Херсонский Вестникгруппа...
Владимир Сальдо рассказал о визите делегации региона на белорусский завод «Амкодор», который он назвал «настоящей кузницей современной техники».«Здесь старинные инженерные традиции переплетаются с новейшими технологиями, а машины выходят такими, что...
ЧП различного характера отмечены в Херсонской области 8-14 сентября. Самые значимые по площади возгорания при этом случились в Скадовском и Каланчакском округах.- За неделю с 8 по 14 сентября пожарно-спасательные подразделения реагировали на...
McDonald’s на Украине — рекордный минусСвыше $40 млн за 2024, пишет Forbes. Логистика, закрытые точки, народ в бегах — зато «символ устойчивости».Енот из Херсона
В Подовской школе Новотроицкого округа прошли занятия на тему «Творчество. Объединяющее».Ребята обсуждали, как искусство объединяет людей разных культур и возрастов, помогает выражать себя и находить общий язык даже без слов.Во время...
Уважаемые тренеры и воспитанники спортивного клуба «Торнадо»! От имени городского спортивного сообщества и от себя лично поздравляю наших замечательных кикбоксеров с блестящей победой на открытом кубке Симферополя! Ваше упорство, сила духа и...
Сегодня в Керчи проводили в последний путь защитника, погибшего в ходе спецоперации. "Андрей Алексеевич Жмак родился в Херсоне. До 15 лет он жил с мамой и бабушкой в Новотимофеевке, Херсонской области. В учебе был прилежным, всегда стремился к новым...
МОСКВА, 15 сен — РИА Новости. Затягивание украинского конфликта обернется еще большими территориальными потерями для Киева, считает американский военный аналитик и бывший офицер морской пехоты Брайан Берлетик. Об этом он написал в соцсети Х....
. Ну не с пустыми же руками возвращаться домой
Подарок для торнадовцев!На минувшей неделе наш округ посетил первый заместитель губернатора Херсонской области Павел Шувалкин.В связи с тем, что наши спортсмены были на соревнованиях в Симферополе, Павел Валерьевич не успел лично посетить спортивный...
"Для Херсонской области сотрудничество с таким передовым партнером имеет особое значение. Обсуждаем поставки современного медицинского оборудования, запуск совместного производства оптических медицинских приборов, создание новых рабочих мест", -...